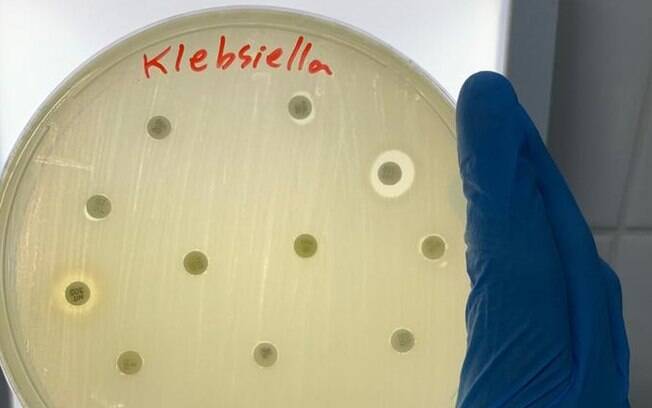
Klebsiella pneumoniae faz parte de categoria 'crítica' das bactérias contra as quais o desenvolvimento de novos remédios é mais urgente, segundo lista da OMS

Um problema declarado há anos como uma das maiores ameaças para a saúde global se depara agora com uma pandemia. O resultado, como é de se imaginar, deverá ser altamente preocupante.
Pesquisadores e médicos atentos ao problema da resistência de bactérias e fungos acreditam que o uso desenfreado de antibióticos no tratamento de Covid-19 tornará ainda mais drástico o cenário atual, em que já há falta de antibióticos capazes de combater certas doenças e micro-organismos — que, por vários fatores, têm se mostrado fortes e hábeis em driblar esses medicamentos.
Antes da pandemia, a situação já era preocupante: no cenário mais drástico, até 2050, a chamada resistência microbiana (doenças resistentes a antibióticos) poderá estar associada a 10 milhões de mortes anuais, afirmou a Organização Mundial da Saúde (OMS) em 2019. Hoje, acredita-se que pelo menos 700 mil pessoas morrem por ano devido à essa resistência microbiana.
Muitos problemas comuns de saúde, como pneumonia e infecção urinária, já têm seus tratamentos dificultados por conta da resistência. Há também condições de saúde mais graves afetadas pelo problema, como a tuberculose multirresistente (com resistência a pelo menos dois antibióticos, isoniazida e rifampicina).
Mas inúmeros estudos pelo mundo têm mostrado que, mesmo sem eficácia e necessidade comprovadas para combater a Covid-19 , antibióticos foram amplamente usados durante a pandemia — e a "conta" poderá ser cobrada nos próximos anos com uma resistência microbiana ainda mais aumentada.
"Já tínhamos o problema da resistência microbiana antes. Em virtude da covid-19, muitos antibióticos foram receitados. Em um futuro não muito distante vamos ter um problema mais sério do que já teríamos", resume Victor Augustus Marin, professor da Universidade Federal do Estado do Rio de Janeiro (Unirio) e pesquisador na área de ciências biológicas.
"Vamos ver efeitos daqui a seis meses, daqui a um ou dois anos, quando pacientes com outras doenças chegarem ao hospital. O médico vai prescrever um antibiótico que pode não funcionar naquele paciente, ou vai aumentar a resistência (de micro-organismos presentes no grupo da pessoa)", prevê Marin, responsável pelo Laboratório de Controle Microbiológico de Alimentos da Escola de Nutrição (Lacomen) da universidade.
Preocupada com esse futuro, a OMS publicou em maio um guia para tratamento de covid-19 que, entre outros pontos, recomendou expressamente a não utilização dos antibióticos no tratamento da nova doença em casos suspeitos ou leves. Mesmo para casos moderados, a entidade indicou que o uso só deve ser feito após indícios de uma infecção bacteriana.
"O uso generalizado de antibióticos deve ser desencorajado, uma vez que sua aplicação pode levar a taxas maiores de resistência bacteriana, o que vai impactar o volume de doenças e mortes durante a pandemia de covid-19 e além", diz o documento da OMS.
Médico do Hospital Sírio-Libanês, em São Paulo, Luciano Cesar Pontes de Azevedo explica que o que se observa nos hospitais e tem sido documentado em pesquisas científicas pelo mundo é o uso de antibióticos com a justificativa não de tratar a infecção causada pelo coronavírus diretamente — mas sim uma eventual infecção concomitante por alguma bactéria.
"Isso (uso de antibióticos no tratamento de Covid-19 ) vem muito do fato de que é uma doença nova, e ninguém conhecia a taxa de coinfecção (por bactérias). Para influenza, a gripe comum, pode ter coinfecção em 30 a 40% dos casos. Para covid-19, estudos têm sugerido de 5 a 7,5% de coinfecção", explica Azevedo, que trabalha com medicina intensiva e medicina de emergência e tem doutorado pela Universidade de São Paulo (USP) e pós-doutorado pelo Instituto Nacional do Câncer (Inca).
"Quando se sabe que a taxa de coinfecção é baixa, não precisa passar antibiótico para todo mundo com covid — como quem está em ambulatório, ou se tratando em casa."
A conduta de médicos e hospitais deve ser receitar antibióticos apenas após uma infecção por bactérias ou fungos realmente ser constatada, preferencialmente por exame de cultura bacteriana e ainda exames que permitem detectar genes de resistência a certos antibióticos.
Diversas pesquisas mostram que essa prudência não foi adotada por muitos profissionais e hospitais. Um estudo envolvendo 38 hospitais do Estado de Michigan, nos Estados Unidos, mostrou que 56,6% de 1.705 pacientes hospitalizados com Covid-19 logo receberam antibióticos como terapia "empírica" — quando não há identificação de qual bactéria ou fungo está causando infecção. Dessas pessoas, apenas 3,5% tiveram uma coinfecção bacteriana confirmada por exames.
Outro estudo, com dados de 99 pacientes tratados no hospital Jinyintan de Wuhan (cidade chinesa onde começou a pandemia), mostrou que 71% deles receberam antibióticos, mas apenas 1% teve coinfecção por bactéria constatada por exames e 4% por fungos.
Com respostas de 166 médicos de 23 países, outra pesquisa constatou que apenas 29% dos profissionais escolheram não receitar antibióticos para pacientes com covid-19 hospitalizados em leitos (menos graves do que aqueles na UTI).
Já na UTI, o antibiótico mais prescrito foi a associação piperacilina/tazobactama. Esta combinação é um antibiótico do tipo inibidor de beta-lactamase, uma classe incluída pela OMS na categoria mais urgente ("criticamente importante") na busca por medicamentos substitutos que consigam driblar a resistência.
Há diversas pesquisas pelo mundo mostrando que bactérias originalmente alvos deste antibiótico, como a Escherichia coli e a Klebsiella pneumoniae, estão ficando resistentes a ele. Um tipo da Klebsiella pneumoniae , a KPC — sigla para Klebsiella pneumoniae produtora de carbapenemase — ficou conhecida como "superbactéria" por produzir uma enzima capaz de combater os medicamentos mais potentes para tratar de infecções graves, com destaque para os chamados carbapenêmicos.
Na pandemia de coronavírus, foi relatado um uso variado de antibióticos , incluindo também a moxifloxacina, medicamentos da classe dos carbapenemas, quinolonas, entre outros.
Antibiótico associado à cloroquina
Enquanto muitos antibióticos foram usados para evitar coinfecções — independentemente se elas existiam de fato ou não —, houve um antibiótico específico muito usado na pandemia e que teria uma outra função, a de fortalecer o sistema imunológico no combate ao coronavírus.
A azitromicina foi o segundo medicamento mais receitado no tratamento da covid-19 por médicos de todo o mundo que participaram de um levantamento da Sermo, uma plataforma mundial usada por estes profissionais. O antibiótico foi prescrito por 41% dos 6,2 mil entrevistados contra o novo coronavírus, atrás apenas dos analgésicos.
O médico Luciano Cesar Pontes de Azevedo explica que, normalmente, a azitromicina é usada com antibiótico contra infecções bacterianas nas chamadas vias aéreas superiores, como no nariz e na garganta. Entretanto, para algumas doenças, já foi sugerido que o antibiótico poderia ter também efeito anti-inflamatório, controlando uma reação exagerada do sistema imunológico — que, na covid-19, é um dos principais caminhos para quadros mais preocupantes.
Para Azevedo, um grande impulsionador da azitromicina no tratamento de coronavírus foi um estudo da França que mostrou o que seriam resultados benéficos da associação deste antibiótico com a hidroxicloroquina, envolvendo cerca de 30 pacientes.
Divulgado em maio na plataforma medRxiv (em que são postados trabalhos sem a chamada revisão dos pares), o trabalho foi dias depois retirado do ar a pedido dos próprios pesquisadores, com a seguinte justificativa: "Por conta da controvérsia sobre a hidroxicloroquina e da natureza retrospectiva desse estudo, os autores pretendem revisar o manuscrito após a revisão dos pares".
Em setembro , Azevedo fez parte de uma coalizão de cientistas brasileiros que publicou na prestigiada revista científica Lancet um estudo clínico refutando os benefícios da azitromicina para pacientes graves com covid-19. O mesmo grupo de pesquisadores já tinha afastado antes, com outro trabalho, a utilidade da hidroxicloroquina associada à azitromicina.
Esta faz parte da classe dos macrolídeos, que está na categoria de maior urgência na classificação da OMS. A resistência à azitromicina pode afetar o tratamento de doenças como otite e gonorreia.
Representando empresas nacionais e internacionais do setor, a Associação da Indústria Farmacêutica de Pesquisa (Interfarma) respondeu à BBC News Brasil por e-mail que o uso off label (diferente daquele que está documentado na bula) de medicamentos é "de inteira responsabilidade do médico, que pode achar necessário de acordo com as necessidades clínicas de seu paciente, mesmo sabendo que essa indicação ainda não foi aprovada".
Entretanto, a associação reconheceu também a excepcionalidade da crise sanitária atual, afirmando que "não tendo vacina ou um tratamento eficaz contra a Covid-19 , alguns protocolos têm adotado o uso off label de antibióticos e outros medicamentos".
A Interfarma não respondeu como avalia o uso empírico de antibióticos (sem constatação do micro-organismo causando infecção) e destacou que a OMS "promove o princípio do uso racional de medicamentos, ou seja, que o paciente receba tratamento apropriado para suas necessidades clínicas".
Como uso desenfreado de antibióticos para covid-19 teria efeitos negativos, na prática?
Os pesquisadores entrevistados pela reportagem explicam que os efeitos preocupantes do amplo uso de antibióticos na pandemia poderiam se expressar tanto nos pacientes individualmente como a nível comunitário, como em hospitais e vizinhanças.
Segundo Victor Augustus Marin, receber um antibiótico sem um diagnóstico preciso pode acabar desestabilizando a comunidade de micro-organismos que existe naturalmente em nosso corpo, como na flora intestinal — formando uma "microbiota".
"Em condições normais, nossa microbiota está em simbiose. Quando você ingere um antibiótico, o que causa? A disbiose: alguns micro-organismos são eliminados, enquanto outros crescem. Crescem aqueles que têm resistência, e antes estavam inibidos pelo resto da microbiota", explica o pesquisador da Unirio.
"Dar um antibiótico sem diagnóstico é como dar um tiro de bazuca em uma mosca — pode até matar a bactéria, mas pode criar resistência em outras que já estavam no organismo (naturalmente). É preciso dar um tiro de chumbinho primeiro para ver se funciona."
Luciano Cesar Pontes de Azevedo diz que "com toda a certeza" esse amplo uso de antibióticos durante a pandemia terá também efeitos mais amplos na população.
"Esses antimicrobianos que estamos usando indiscriminadamente, como a azitromicina e a claritromicina, aumentam na comunidade a chance de bactérias resistentes, como as que causam pneumonias. Possivelmente, quando chegarem pneumonias de comunidade daqui a dois, três anos, vamos precisar começar usando antibióticos mais fortes", prevê o médico.
Pesquisadores costumam falar em micro-organismos resistentes na "comunidade" para quando eles já são detectados fora dos hospitais.
Isso porque, dentro destes ambientes, bactérias e fungos resistentes são particularmente preocupantes.
Uso de antibióticos em casos graves de covid-19
Azevedo acrescenta que, além da coinfecção por uma bactéria ou fungo, existe também a possibilidade de uma superinfecção .
"É quando, em uma fase mais tardia da Covid-19 , o paciente é contaminado por germes hospitalares. Acontece fundamentalmente com pacientes de Unidades de Terapia Intensiva (UTI), graves, que já têm um grau de deficiência do sistema imunológico", explica o médico.
Ainda que um paciente no ambiente hospitalar possa estar sujeito a micro-organismos mais resistentes, Azevedo diz que mesmo assim o uso de antibióticos deve ser criterioso — sendo precedido por exames e modulado, se possível, para tempos mais curtos.
Uma equipe do Hospital Israelita Albert Einstein, em São Paulo, publicou em agosto dados sobre 72 pacientes com covid-19 que foram internados em UTIs ou receberam cuidados intensivos — mostrando que 84,7% deles receberam antibióticos intravenosos durante a internação, sendo o tipo de medicamento mais usado neste grupo de pacientes.
Infectologista do hospital, Fernando Gatti aponta que, enquanto para pacientes com covid-19 em geral a coinfecção pode ser menor que 10%, para pacientes mais graves esse percentual sobe para cerca de 30%.
"O que acontece? O vírus tem ação inicialmente lesiva no pulmão. As bactérias que fazem parte da colonização do trato respiratório acabam tendo mais facilidade para invadir o tecido pulmonar", explica Gatti.
"A pneumonia pode então ser complicada por uma infecção bacteriana, o que aumenta o tempo na ventilação mecânica, UTI, catéter..."
Assim, ele explica que no Albert Einstein o procedimento para pacientes graves com covid-19 é a administração de antibióticos venosos de "amplo espectro" (que atingem uma variedade de patógenos) mesmo sem exames detalhando uma possível coinfecção por bactéria — a chamada terapia "empírica".
Depois, com os exames de cultura bacteriana em mãos, a equipe então usa antibióticos mais específicos considerando os micro-organismos e suas resistências.
É um cuidado tomado justamente para evitar a exposição longa a antibióticos que possam acabar fortalecendo as bactérias e fungos.
Luciano Cesar Pontes de Azevedo diz que, para pacientes que tiveram quadros mais graves de covid-19, a resistência se torna um problema ainda mais delicado porque doenças crônicas e sequelas podem deixar mais fraco o sistema respiratório — e, assim, mais vulnerável a novas infecções.
Se reconhece que para pacientes graves, a administração de antibióticos é mais "difícil de criticar" pois muitas vezes responde a uma questão de vida e morte, Azevedo diz que o uso generalizado de antibióticos na pandemia mostra que ainda falta adesão a um problema que é na verdade uma ameaça global.
"Acho que a pauta da resistência microbiana não foi incoporada por profissionais de saúde e pelos governos. E se trata também de uma pauta que envolve não só o ambiente hospitalar, mas também a agropecuária", destaca o médico.
Conforme mostrou a BBC News Brasil em 2019 , pesquisadores têm mostrado cada vez mais como micro-organismos e resquícios de antibióticos não têm fronteiras — possivelmente se alastrando pelos alimentos, lixo hospitalar, rios e canais de esgotos.
"Infelizmente, a covid-19 não veio para ajudar nisso, pelo contrário", lamenta Azevedo.
